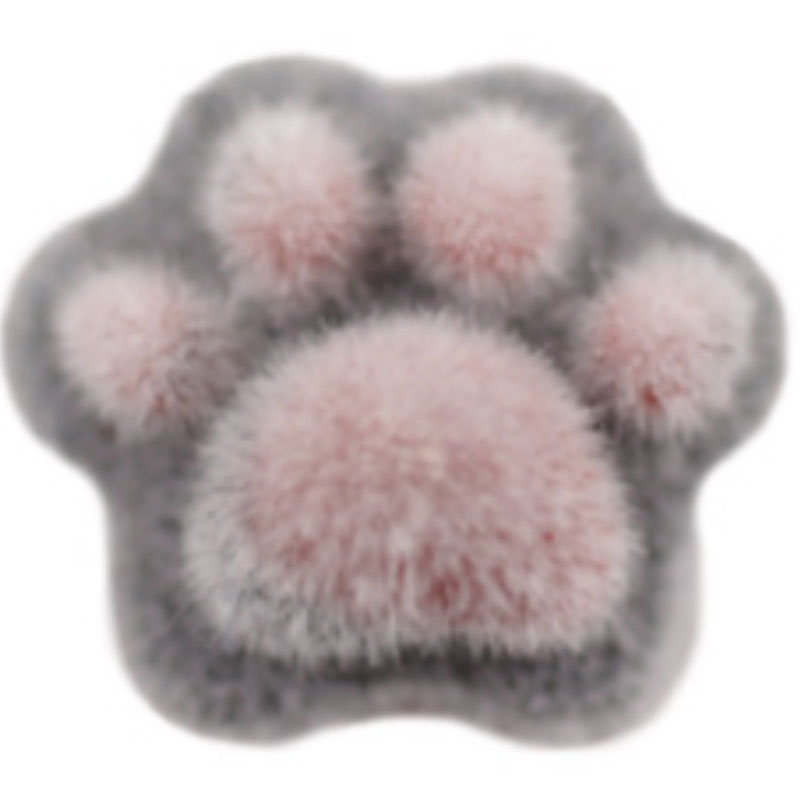
ふわもこ肉球 ブラック【お取り寄せ】【ゆうパケット】

商品コード:
171-MA-406400000
容量:
4pcs
JANコード:
4580583904064
商品説明
起毛素材の立体パーツで質感の違いを楽しめるデザインアクセントに。
トレンドのもこもこアートやモチーフネイルにもピッタリです。
温かみと遊び心をひとつにした、ほっこりかわいいパーツです。
サイズ:1.0㎜×1.0㎜
厚み:約5㎜
背面カーブなし
※製造ロットによって多少の色味や形状、個体のサイズが異なる場合がございます。
※印刷物やPCの環境等によって、色味が現物と異なる場合がございますが、その際は現物を優先させていただきます。
トレンドのもこもこアートやモチーフネイルにもピッタリです。
温かみと遊び心をひとつにした、ほっこりかわいいパーツです。
サイズ:1.0㎜×1.0㎜
厚み:約5㎜
背面カーブなし
※製造ロットによって多少の色味や形状、個体のサイズが異なる場合がございます。
※印刷物やPCの環境等によって、色味が現物と異なる場合がございますが、その際は現物を優先させていただきます。